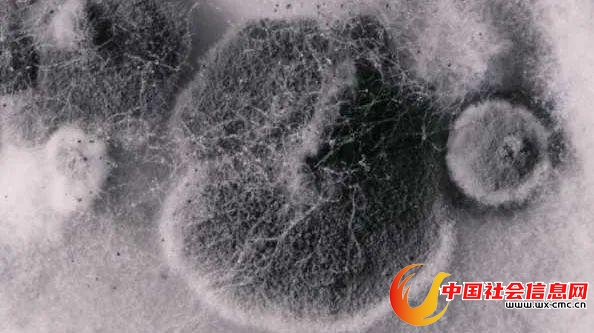

仔细看看,你家里有没有这种小黑点?

这种小黑点,其实是小霉点,由霉菌造成。霉菌不仅影响美观,还对人体呼吸系统、皮肤、肠道等有潜在威胁。家中哪些地方容易藏匿霉菌?如何应对?今天就来讲清楚。
夏天是霉菌活跃的季节
霉菌,是一种特殊的真菌,能够引起霉变反应。霉菌有数万种,其中有30种左右寄居在家里,最常见的室内霉菌是枝孢菌、青霉菌和曲霉菌。
有的霉菌有潜在致癌风险,比如黄曲霉菌能分泌黄曲霉毒素,这种毒素的毒性是砒霜的几十倍。
盛夏来临,气温升高,雨水增多,又潮又热,霉菌也迎来了“快乐”的日子。一般来说,温度20℃~35℃、相对湿度75%以上,比较适合霉菌生长。其中,“梅雨天”霉菌的滋生速度是其他季节的4倍。
出现小霉点,伤害一连串
家里出现小霉点,对健康有潜在威胁,其危害很多人忽视了。
侵袭呼吸系统
比如,黑曲霉多附着在潮湿的淋浴间及洗漱台周围,容易侵袭孩子、老人或免疫力较弱的人群,诱发呼吸系统疾病和肺病;瓜枝孢多附着在墙面,或浮在空气中,易引发哮喘和呼吸系统疾病。

像烟曲霉等特定霉菌,对免疫力较弱的人,还可能带来致命的肺部感染。
烟曲霉被世界卫生组织列入首份真菌“重点病原体”清单,侵袭性曲霉菌病一旦发生就是危重症。腐烂的落叶上很可能就附着了烟曲霉。
诱发过敏
霉菌还是重要的过敏原,它能形成网状的菌丝体,产生大量孢子。
霉菌孢子体积小,在空气中容易飞散,有些人会出现眼睛皮肤发红发痒、鼻塞、咳嗽等情况。
北京同仁医院曾对门诊过敏性鼻炎患者统计发现,霉菌(下图中红色的三角形折线)是过敏性鼻炎的重要原因之一,且夏季更活跃。

引起胃肠炎
霉菌本身容易造成感染,比如我们常说的脚癣和由念珠菌引发的食道炎及胃肠炎等。
侵袭血管
复旦大学附属中山医院感染科曾接诊过一位因咯血就诊的患者,支气管镜检查显示,患者肺部有炎症,微生物学检查发现了烟曲霉菌。
简单来说,就是曲霉菌使肺部发霉了。曲霉菌会侵犯血管,所以有咯血症状,如果任其发展,肺的结构会毁损,甚至出现大量咯血。

霉菌爱藏在5个地方
霉菌大量繁殖主要有4个条件:①温度超过20℃;②湿度70%以上;③垃圾和灰尘等为其提供“营养源”;④氧气充足。基于霉菌的生存条件,家里以下地方更容易藏匿霉菌。
1、卫生间及浴室
尤其是卫生间的墙角、瓷砖缝、水龙头、浴室帘子、浴室密封胶等处,都可能出现霉菌。
建议:加装并使用排风扇;洗澡后,可以先用热水冲刷浴缸侧面和墙壁,再用冷水冲刷一遍;及时拖干地面水渍,保持卫生间干燥卫生。
2、冰箱
重点包括冰箱的密封条、底座、冰箱内部。冰箱的密封条容易滋生一种叫链格孢的霉菌,它能引发吸入性过敏。带土的蔬菜放在冰箱里,泥土中所含的霉菌可随空气循环转移到其他食材上。
建议:每个月定期清洗冰箱,尤其注意擦洗密封条。平时生熟食物分开放,避免冰箱装太满。
3、洗衣机
洗好的衣服忘记及时取出、用完洗衣机就把盖子扣上等习惯,给了霉菌繁殖的好机会。
建议:定期清洁洗衣机内筒,尤其梅雨季,可以用专门的清洗剂给内筒消毒。
4、菜板
很多家庭会选用木制或竹制的菜板,若清洗不到位,就易发霉。
建议:菜板、锅具、碗碟等清洗后,及时擦干。做完饭后,尽快清理厨余垃圾。
5、卧室及阳台
尤其是阳台、空调和寝具。
很多家庭会在阳台养花、晾衣服,所以阳台的边边角角易滋生霉菌;
空调内湿气聚积,也容易发霉,使用前最好先清洗;
人一夜间约产生180毫升的汗,若不注意通风和晾晒,床垫等寝具也易发霉。
建议:对于寝具的霉菌,可将空调设定在25℃左右,开启除湿模式。还可以多晒被子,通风换气。
家里出现霉菌如何清除?
霉菌通常可通过高温(水温80℃以上、阳光暴晒等)、按说明书配置84消毒液(不要和洁厕灵等清洁剂混用)等方式杀灭。
对于墙体发霉,北京清洁协会专家张永红表示,如果霉点不严重,可用抹布直接擦掉,也可用漂白水喷雾(有颜色的墙面慎用);如为墙纸,不能用水擦,要用布浸点酒精抹拭。
霉菌滋生受温度、湿度影响,保持清洁和干燥,是解决霉菌问题的关键。生活中可注意以下几点:
1、关注重点场所
尤其是空调、水槽排水孔、冰箱底盘、菜板、浴缸或瓷砖缝、窗边、墙壁、天花板、植物盆栽等地方。
2、适当除湿
控好湿度能减少霉菌滋生。
雨季可适当使用除湿机,或打开空调的除湿模式;
可以准备一湿一干两个拖布,并尽量用干拖布将地面擦干;
洗澡后开启换气扇,并及时清理地上的水;
室外较潮湿时,少开门窗。
3、经常通风
保持家中通风良好,浴室尽量安装换气设备。经常通气还能稀释空气中的霉菌孢子,降低潜在危害。需要提醒的是,在进行除霉操作时,最好佩戴手套、口罩,并开窗通风。
【编辑:陈雪梅】